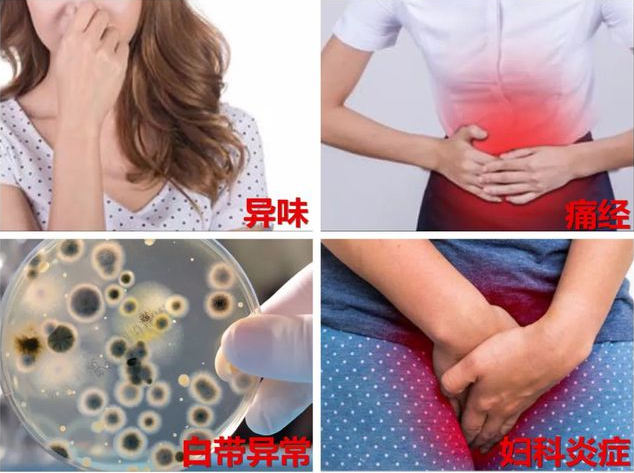

威海专业治阴道炎的医院 阴道炎治疗期间要注意什么
2023-03-23 19:17:34
威海专业治阴道炎的医院
阴道炎给很多患者造成了严重的困扰,要早发现早治疗,治疗阴道炎建议到当地专业的医院进行系统治疗,可有效改善病情。缓解疾病对患者造成的痛苦。
阴道炎的症状早期发现很重要
女性阴道的解剖学特性,使得极易受到病菌感染,因此阴道炎的症状也成为了妇科炎症中为常见的一种。对于不同病因引起的阴道炎来说,其阴道炎的症状也是有着一定区别的,要注意分辨。
1、霉菌性阴道炎的症状
霉菌性阴道炎是女性发病率是高也是常见的,现状也非常明显。外阴瘙痒,外阴及阴道灼痛,白带增多呈豆腐渣样,有时伴有尿频、尿频、尿痛,妇科检察时可见小阴唇内侧及阴道粘膜上附着白色膜状物,擦除后露出红肿粘膜面,急性期可见受损的糜烂面或表浅溃疡。
2、非特异性阴道炎的症状
阴道有下坠感,灼热,伴有盆腔不适及全身乏力。阴道分泌物增多,呈脓性、浆液性,有臭味。由于分泌物刺激尿道口,可引起尿频、尿急、尿痛。
3、老年性阴道炎的症状
白带增多,色黄,呈水状,严峻时呈脓性,有臭味,有时可有血性或伴点滴出血,外阴有瘙痒或灼热感,干痛,下腹部坠胀,波及尿道时,有尿频、尿急、尿痛等。
阴道炎治疗期间要注意什么
一、要注意卫生。治疗阴道炎期间要保持外阴清洁,坚持每日换内裤,而且好穿宽松的棉质裤衩,以保持阴道透气、干燥,不与他人共用浴巾、浴盆。治疗期间禁止性交,或采用避孕套以防止交叉感染
二、要夫妻同治。丈夫或性伴应同时进行针对性治疗,防止病人反复感染。
三、禁止搔抓。在阴道炎治疗期间,很多女性会出现阴部瘙痒,此时切勿用力抓搔,防止出血、红肿,勿用热水烫洗,以免烫伤。
四、避免使用抗生素。抗生素并不是的,或许很多女性遇上该疾病,首先会考虑到使用抗生素来治疗。使用抗生素过多会破坏阴道菌群的平衡关系,加大阴道炎的治疗难度,所以女性朋友治疗阴道炎不要擅自使用抗生素。
五、注意饮食调理。治疗期间要避免辛辣刺激性食物,还有应禁止抽烟、喝酒、海鲜发物、甜腻厚味等食物。防止加重阴道炎症、充血。每天多喝水、多吃新鲜的瓜果蔬菜。
免责声明:本页面信息为第三方发布或内容转载,仅出于信息传递目的,其作者观点、内容描述及原创度、真实性、完整性、时效性本平台不作任何保证或承诺,涉及用药、治疗等问题需谨遵医嘱!请读者仅作参考,并自行核实相关内容。如有作品内容、知识产权或其它问题,请及时联系我们处理!